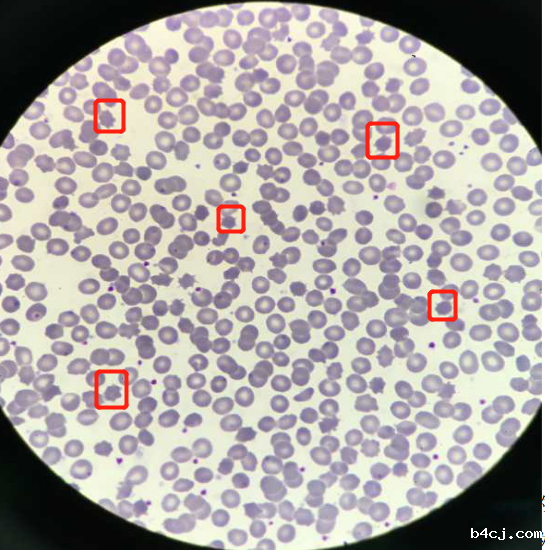
1592875136869705.png 图片12.png

【工作手记】棘形红细胞引发的 “巧合”
早交班时每天进行细胞形态学考核,是检验科的惯例。前几天早上考核的细胞形态是外周血涂片中的棘形红细胞和椭圆形红细胞,今早交完班,回到工作岗位不久,接到了来自神经内科医生打来的电话,要求检查一名患者的外周血红细胞形态,主要计数棘形红细胞的比例。
外周血细胞形态丰富,往往要求单独计数棘形红细胞的数量几乎很少碰到。询问医生该病人基本病情,了解到该病人血常规结果没有异常,但心肌酶的几项结果都高,临床表现为震颤、不自主的咬舌等。难道和我们早上考核的棘形红细胞临床意义中的某一罕见病相似么,真的会这么巧吗?
带着疑惑,收到了该病人的标本后,立即涂片、染色、镜检,镜下检查一看,有较多红细胞的表面有针尖状突起,其间距不规则,突起的长度和宽度都不规则,这不就是典型的棘形红细胞!计数了1000个红细胞,棘形红细胞有160个,占比为16%。如此高的棘形红细胞我也是第一次遇到,这是否与罕见的舞蹈——棘红细胞增多症有关?
舞蹈——棘红细胞增多症(ChAc)是一种以进行性运动增多伴有棘红细胞增多为主要临床特征的神经系统变性疾病,以常染色体隐性遗传多见,少数可呈常染色体显性遗传。舞蹈样动作是患者最特征性的运动障碍,表现为突然地,不自主运动,也常累及口面部,导致咬舌和咬指头等,该病的诊断主要靠临床表现和辅助检查,其中外周血的棘红细胞>4%,血清CK增高。但确诊需要进行基因分型。结合这个病人的临床表现,与该病极其吻合,于是联系医生告知我们的检查结果,询问临床是否考虑是舞蹈-棘红细胞增多症,医生说目前各项数据都很支持该病。
小小细胞,大大用途,在这个科技发展迅速的时代随着电脑图文技术的不断推进和自动化仪器的应用越来越普遍,但血涂片镜检是不可取代的,如果过分依赖自动化的仪器会导致部分病例漏检、漏报等,会影响临床的诊断,由此可见,细胞形态学检查在疾病的诊疗中占有重要的一席之地。
检验科:杨慧